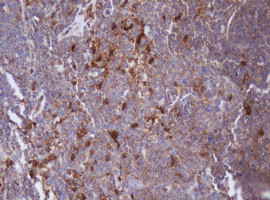
IDH1 Antibody in Immunohistochemistry (Paraffin) (IHC (P))

Search
OriGene
IDH1 Monoclonal Antibody (OTI24A2), TrueMAB™
{{$productOrderCtrl.translations['antibody.pdp.commerceCard.promotion.promotions']}}
{{$productOrderCtrl.translations['antibody.pdp.commerceCard.promotion.viewpromo']}}
{{$productOrderCtrl.translations['antibody.pdp.commerceCard.promotion.promocode']}}: {{promo.promoCode}} {{promo.promoTitle}} {{promo.promoDescription}}. {{$productOrderCtrl.translations['antibody.pdp.commerceCard.promotion.learnmore']}}
产品信息
CF800426
种属反应
宿主/亚型
分类
类型
克隆号
抗原
偶联物
形式
浓度
规格
纯化类型
保存液
内含物
保存条件
运输条件
产品详细信息
For reconstitution, we recommend adding 100 µL distilled water to a final antibody concentration of about 1 mg/mL. To use this carrier-free antibody for conjugation experiments, we strongly recommend performing another round of desalting. (Zeba Spin Desalting Columns, 7KMWCO, 0.5 mL, Product # 89882)
靶标信息
Isocitrate dehydrogenases such as IDH1 catalyze the oxidative decarboxylation of isocitrate to 2-oxoglutarate. These enzymes belong to two distinct subclasses, one of which utilizes NAD(+) as the electron acceptor and the other NADP(+). Five isocitrate dehydrogenases have been reported: three NAD(+)-dependent isocitrate dehydrogenases, which localize to the mitochondrial matrix, and two NADP(+)-dependent isocitrate dehydrogenases, one of which is mitochondrial and the other predominantly cytosolic. Each NADP(+)-dependent isozyme is a homodimer. The protein encoded by this gene is the NADP(+)-dependent isocitrate dehydrogenase found in the cytoplasm and peroxisomes. It contains the PTS-1 peroxisomal targeting signal sequence. The presence of this enzyme in peroxisomes suggests roles in the regeneration of NADPH for intraperoxisomal reductions, such as the conversion of 2, 4-dienoyl-CoAs to 3-enoyl-CoAs, as well as in peroxisomal reactions that consume 2-oxoglutarate, namely the alpha-hydroxylation of phytanic acid. The cytoplasmic enzyme serves a significant role in cytoplasmic NADPH production. This product is specific for IDH1 (mutant R132H).
仅用于科研。不用于诊断过程。未经明确授权不得转售。
篇参考文献 (0)
生物信息学
蛋白别名: Cytosolic NADP-isocitrate dehydrogenase; epididymis luminal protein 216; epididymis secretory protein Li 26; epididymis secretory sperm binding protein; homodimer; IDH; IDH1; IDH1-mutant; IDP; IDPc; isocitrate dehydrogenase (NADP(+)) 1, cytosolic; isocitrate dehydrogenase 1 (NADP+), soluble; Isocitrate dehydrogenase 1, soluble; Isocitrate dehydrogenase [NADP] cytoplasmic; NADP(+)-specific ICDH; NADP-dependent isocitrate dehydrogenase, cytosolic; NADP-dependent isocitrate dehydrogenase, peroxisomal; Oxalosuccinate decarboxylase; PICD; soluble; NADP+-dependent; unnamed protein product
基因别名: AI314845; AI788952; E030024J03Rik; HEL-216; HEL-S-26; Id-1; IDCD; IDH; Idh-1; IDH1; IDP; IDPC; PICD
UniProt ID: (Human) O75874, (Mouse) O88844, (Rat) P41562
Entrez Gene ID: (Dog) 478889, (Human) 3417, (Mouse) 15926, (Rat) 24479